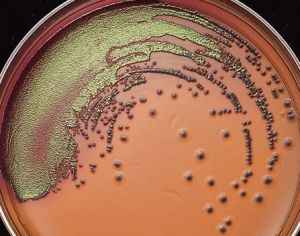
伊紅美藍培養基

原理
伊紅美藍培養基在鹼性環境中不分解乳糖產酸的細菌不著色,伊紅和美藍不能結合,故沙門氏菌等為無色或琥珀色半透明菌落。金葡菌在此培養基上不生長。
常用的伊紅美藍乳糖培養基,可用來鑑別飲用水和乳製品中是否存在大腸桿菌等細菌。如果有大腸桿菌,因其強烈分解乳糖而產生大量的混合酸,菌體帶H+,故菌落被染成深紫色,從菌落表面的反射光中還可以看到金屬光澤。
鑑定方法
用伊紅美藍培養基鑑定水中大腸桿菌步驟如下:
①製作伊紅美藍培養基,趁熱注入培養皿中,凝成平板,待用。
②用滅過菌的錐形瓶盛取河水或溝水,按1:10稀釋。
③取0.1毫升稀釋液接種於伊紅美藍培養基上。用平板劃線分離法進行分離。
④將劃線後的培養皿倒置37℃溫箱中培養18~24小時。培養基中會出現大腸桿菌菌落,菌落中心呈暗藍黑色,發金屬光澤。
⑤將菌落接種於斜面培養基上(由營養瓊脂培養基製成)。
配置方法
配方
蛋白腖 10g乳糖 10g
磷酸氫二鉀 2g
瓊脂 20~30g
蒸餾水 1000ml
2%伊紅水溶液 20ml
0.5 %美藍水溶液 13ml